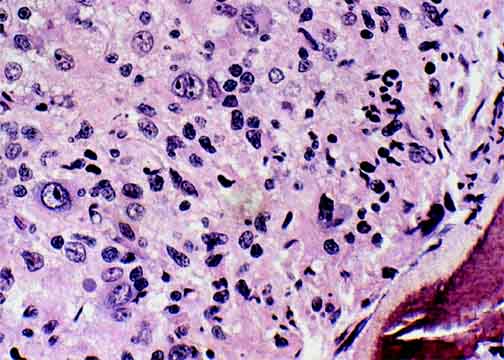

Go to:

TOC
|
Peripheral T-Cell Lymphomas: Example 5B
This lymphoma is shown outside the marrow as Case 5A.

At this relatively low power, it's hard to discern much detail. The marrow
is hypercellular and induces an uneasy impression of disorganization, to say
the least.
|
Here the highly atypical cells seen in the
lymph node are present in
the marrow. A scrap of bone is glimpsed at the lower right.
|
Table of Contents
|